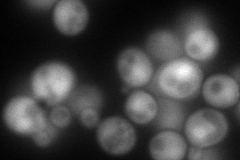
YPR103W
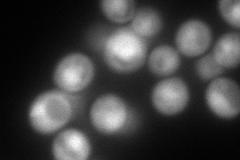
YPR103W
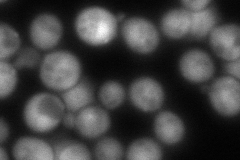
YPR103W
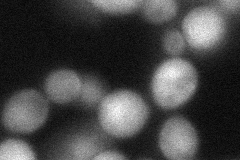
YPR103W
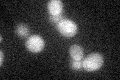
YPR103W
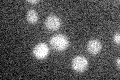
YPR103W

View description
Beta 5 subunit of the 20S proteasome, responsible for the chymotryptic activity of the proteasome
Localization:
Intensity:
Fold change:
Significance:
-
C’ GFP library in SD

below threshold17.1 -
N' NOP1pr-GFP in SD
cytosol,nucleus200.401 -
N' TEF2pr-mCherry in SD
cytosol,punctate,nucleus209.069 -
N' NATIVEpr-GFP in SD
punctate,nucleus180.853 -
N' TEF2pr-VC and Cyto-VN in SD
cytosol50.2611 -
C’ GFP library in SD+DTT
cytosol16.330.95No -
C’ GFP library in SD+H2O2

cytosol15.530.9No -
C’ GFP library in Starvation Media
cytosol15.770.92No -
C’ GFP library on the background of Pup2-DaMP

below threshold -
C’ GFP library on the background of CCT mutant

below threshold19.11491.11711No
